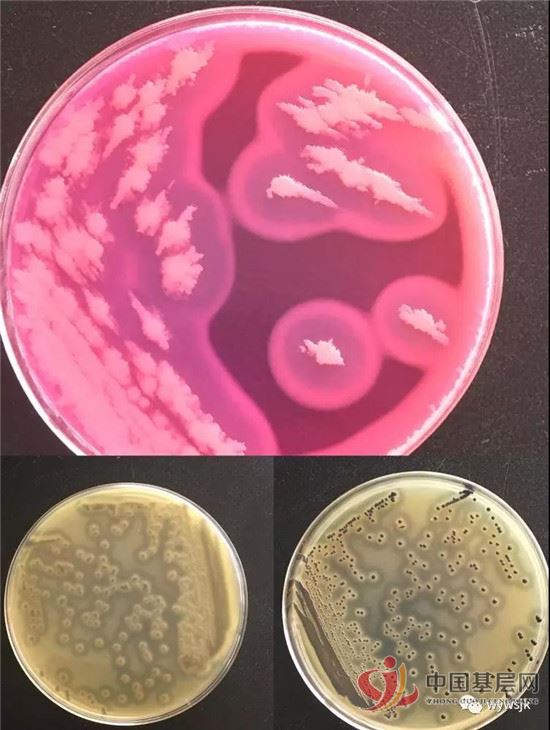
11173364045198021_49.jpg

中国基层网婺源8月11日消息(通讯员 裘峥艳)为了解全县食品(含食品相关产品)中主要污染物及有害因素的污染水平和趋势,发现食品生产、消费环节的食品安全隐患和确定危害因素的分布和可能来源,婺源县疾控中心对全县的各种渠道配送外卖和坚果/籽类的酱,按《2017年国家食品污染物和有害因素风险监测工作手册》的统一标准检测方法进行检测。


据了解,此次监测做到全覆盖原则,一是区域全覆盖,采样要覆盖全县并延伸到农村,二是监测对象全覆,即覆盖食品、食品添加剂、食品相关产品。为了尽快地完成监测检验科人员加班加点,放弃了双休日,现已完成了前两季度样品的检测,共20份餐饮外卖和15份坚果/酱类。

随着国家和社会的稳定发展,食品安全成重大的民生问题,关系人民群众身体健康和生命安全,关系社会和谐稳定,随着生活水平的不断提高,人民群众对食品安全更为关注,“食以安为先”的要求更为迫切,全面提高食品安全保障水平,已成为我国经济社会发展中一项重大而紧迫的任务。